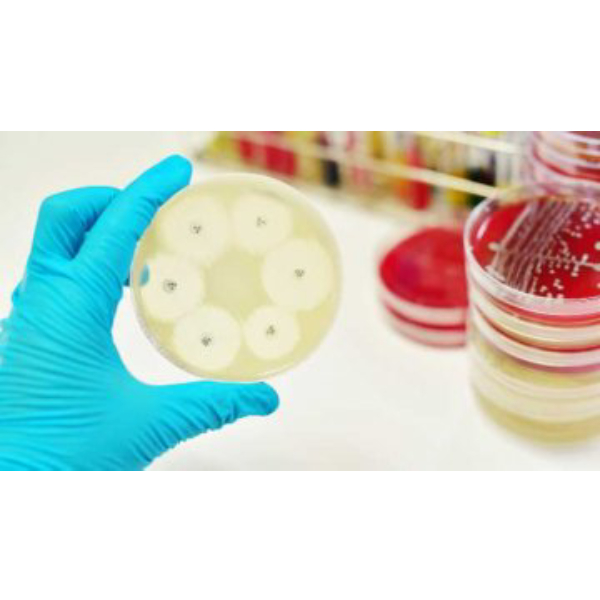

فروش دیسک آنتی بیوتیک آمپی سیلین برند پادتن طب
شرکت اینترنتی تماد کالا که در زمینه فروش اینترنتی مواد و تجهیزات آزمایشگاهی پیشرو می باشد، آماده ارائه خدمات در حوضه فروش تجهیزات آزمایشگاهی با کیفیت عالی، قیمت مناسب و در مقادیر دلخواه مشتریان است. توضیحات دیسک آنتی بیوتیک آمپی سیلین برند پادتن طب را می توانید در بخش های بعدی ملاحظه فرمایید. همچنین برای آگاهی از قیمت می توانید به ابتدای صفحه مراجعه نمایید.
آنتی بیوتیک ها مواد شیمیایی هستند که بطور طبیعی از قارچ ها و باکتری ها استخراج می شوند. برای بررسی میزان حساسیت سویه های مختلف میکروبی به آنتی بیوتیک های مختلف، از دیسک های آنتی بیوگرام استفاده میشود. دیسک آنتی بیوگرام یک تست حساسیت نسبت به آنتی بیوتیک می باشد. هر آنتی بیوتیک بر باکتری مشخصی تاثیر گذار است و بر روی سایر میکروارگانیسم ها تاثیری ندارد. برخی باکتری ها نسبت به برخی آنتی بیوتیک ها مقاوم اند و درمان دارویی را سخت می کنند. برای تشخیص این مقاومت، از دیسک های آنتی بیوگرام هر آنتی بیوتیک استفاده می شود.
تست آنتی بیوگرام شامل سنجش میزان توانایی یک آنتی بیوتیک و یا سایر عوامل ضد میکروبی برای ممانعت از رشد باکتری ها می باشد. این توانایی را می توان با استفاده از روش های رقت سازی در لوله و یا کشت میکروارگانیسم در پلیت اندازه گیری نمود. تست آنتی بیوگرام از تست های پرکاربردی که از پلیت در این روش استفاده میشود. امپی سیلین پادتن طب ،یکی از انواع دیسک های آزمایشگاهی آنتی بیوگرام است. در هر ویال 50 عدد دیسک قرار گرفته است.
آمپیسیلین از داروهای رده پنی سیلین و از دسته بتالاکتام ها است. این دارو همانند آموکسیسیلین از رده آمینو پنیسیلین ها است و خصوصیات مشابهی با آن دارد با این تفاوت که جذب خوراکی کمتری دارد. در درمان عفونت های گوارشی و ادراری و یا به صورت تزریقی استفاده می شود. این دارو با اتصال به پروتئین متصل شونده به پنیسیلین (PBP) باعث مهار ترانس پپتیدازها میشود و باعث ممانعت از ساخت پپتیدو گلیکانهای دیواره سلولی باکتری و تخریب دیواره سلولی باکتری میشود. آمپیسیلین به بتالاکتاماز حساس است و باکتریهای تولیدکننده بتالاکتاماز در برابر آن مقاومند. این دارو علاوه بر عملکرد همانند پنیسیلین به دلیل طیف ضد میکروبی گستره آن، توانایی اثر بر تعدادی از باکتریهای گرم منفی را نیز دارد.
باکتریهای گرم مثبت حساس
- استرپتوکوکها
- پنوموکوک حساس به پنیسیلین
- انتروکوک فکالیس
- گونههای استاف غیرتولیدکننده بتالاکتاماز
- لیستریا (برخلاف پنیسیلین این باکتری بسیار حساس به آمپیسیلین است)
باکتریهای گرم منفی حساس (انواع غیرتولیدکننده بتالاکتاماز)
- هموفیلوس آنفلوآنزا
- نیسریا مننژیتیدیس
- نیسریا گونوره
- ای-کولای
- پروتئوس میرابیلیس
- سالمونلاها
- به طور کلی در مورد باسیل های گرم منفی قویتر از پنیسیلین
مزایای استفاده از روش
- راحت و آسانی کار با آن
- کم هزینه و مقرون به صرفه
- قابلیت تکرارپذیری
- دارای دقت و صحت بیشتر برای گرم منفی ها ،نسبت به سایر روش ها
کاربردهای دیسک آنتی بیوتیک آمپی سیلین برند پادتن طب
- بررسی حساسیت یک سویه ی باکتریایی برای آنتی بیوتیک های گوناگون
- تشخیص صحیح و به موقع باکتری مورد نظر
- تجویز درمان مناسب و قطعی بیماری های عفونی
- سنجش حساسیت دارویی نمونه فرد
نحوه مصرف
- بعد از کشت نمونه دریافتی در محیط کشت مناسب، اگر باکتری در نمونه حضور داشته باشد، رشد خواهد کرد. بعد از رشد باکتری، از آن لام (مقداری نمونه + سرم فیزیولوژِی) تهیه میکنیم تهیه کرده و رنگ آمیزی گرم انجام دهید.
- اگر باکتری جز باکتریهای پاتوژن باشد، باید تست آنتی بیوگرام را انجام شود. مقداری از نمونه را برداشته و در محیط کشت آنتی بیوگرام کشت دهید. سپس دیسکهای آنتی بیوگرامی را روی محیط کشت گذاشته و جواب را بعد از 24 تا 48 ساعت در انکوباتور بررسی کنید.
- غلظت آنتی بیوتیک مورد استفاده در دیسک و قطر هاله عدم رشد باکتری پیرامون دیسک آنتی بیوگرام مورد استفاده، در آنالیز نتایج تست آنتی بیوگرام مهم می باشد.
- نتیجه آزمایش با استفاده از خط کش خوانده میشود و با چارت های آنتی بیوگرام مقایسه میشود.
ابزار احتمالی مورد نیاز جهت انجام تست انتی بیوگرام
- محیط کشت مناسب آگار مولر هینتون
- محیط نیم مک فارلند
- لوله حاوی نیم مک فارلند
- لوله حاوی یک سی سی سرم فیزیولوژی استریل
- دیسک انتی بیوگرام
- باکتری خالص
- سواب،آنس، چراغ الکلی و هود
دو اصطلاح میکروبشناسی کاربردی در روش بیوگرام
- Minimum Inhibitory Concentration (MIC) غلظتی از یک آنتیبیوتیک که میتواند رشد باکتری را در شرایط آزمایشگاهی مهار کند.
- Minimum Bactericidal Concentration (MBC) حداقل غلظتی از دارو که باکتری را از بین میبرد.
خرید دیسک آنتی بیوتیک آمپی سیلین برند پادتن طب
برای آگاهی از جزئیات بیشتر و قیمت دقیق این محصول با کارشناسان تمادکالا تماس بگیرید. شما میتوانید این محصول را از ابتدای صفحه به صورت اینترنتی خریداری کنید.